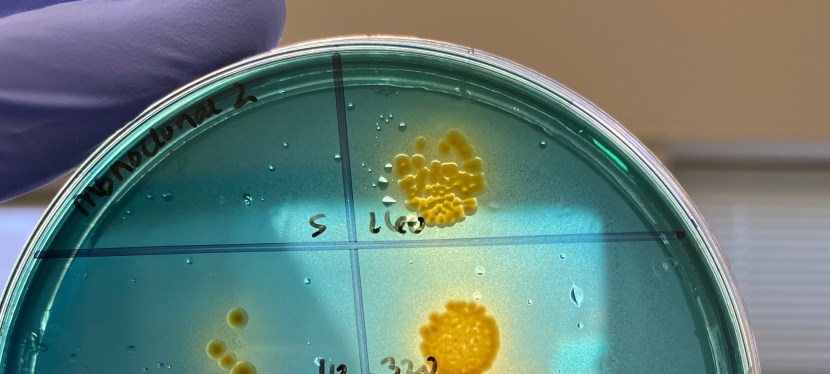
Research

I’ve had the pleasure of touching many different areas in my research career so far, from fostering a deep love for the gut and its ecosystem to a broader passion for public and global health and its intersection with nutrition and infectious disease.
The through line in all of it is a passion for understanding the many layers of human flourishing, starting with our smallest inhabitants in the gut and layering through our immune system, nutrition, access to food and clean water, and supporting a flourishing climate that makes all of these possible. I care about the interconnectedness of human wellbeing, from the microbial to the societal, and have spent my career understanding different facets of this idea.
Currently my work focuses on tracking cholera in endemic and epidemic settings using seroepidemiological tools, and also understanding the immunometabolism of mucosal-associated invariant T (MAIT) cells in different states of malnutrition.
To see an up-to-date list of my research publications, please check out my Google Scholar profile, or peruse the list below*:
*Maiden name: Harrison
- Davis, Kilee L., Carmen Nieznanski, Felicien Maisha, Ben J. Brintz, Christy Clutter, Meer Alam, Cyrus Saleem, Afsar Ali, J. Glenn Morris, and Daniel T. Leung. “Kinetics of vibriocidal antibody responses among cholera patients in Goma, the Democratic Republic of Congo.” medRxiv (2025): 2025-02.
- Ryan, Eimear K., Christy Clutter, Conor De Barra, Benjamin J. Jenkins, Simon O’Shaughnessy, Odhrán K. Ryan, Chloe McKenna et al. “Iron is critical for mucosal-associated invariant T cell metabolism and effector functions.” The Journal of Immunology 212, no. 11 (2024): 1706-1713.
- Clutter, Christy H., Molly B. Klarman, Youseline Cajusma, Emilee T. Cato, Md Abu Sayeed, Lindsey Brinkley, Owen Jensen et al. “Population-Based Serologic Survey of Vibrio cholerae Antibody Titers before Cholera Outbreak, Haiti, 2022.” Emerging infectious diseases 29, no. 9 (2023): 1864.
- Laubitz, Daniel, Michael A. Gurney, Monica Midura-Kiela, Christy Clutter, David G. Besselsen, Hao Chen, Fayez K. Ghishan, and Pawel R. Kiela. “Decreased NHE3 expression in colon cancer is associated with DNA damage, increased inflammation and tumor growth.” Scientific reports 12, no. 1 (2022): 14725.
- Bushman, D., Alroy, K. A., Greene, S. K., Keating, P., Wahnich, A., Weiss, D., Pathela, P., Harrison, C., Rakeman, J., Langley, G., Tong, S., Tao, Y., Uehara, A., Queen, K., Paden, C. R., Szymczak, W., Orner, E. P., Nori, P., Lai, P. A., … Sell, J. (2020). Detection and genetic characterization of community-based SARS-CoV-2 infections – New York City, March 2020. Morbidity and Mortality Weekly Report, 69(28), 918-922. https://doi.org/10.15585/mmwr.mm6928a5
- Jamwal, D. R., Laubitz, D., Harrison, C. A., da Paz, V. F., Cox, C. M., Wong, R., … & Lybarger, L. (2020). Intestinal Epithelial Expression of MHCII Determines Severity of Chemical, T-Cell–Induced, and Infectious Colitis in Mice. Gastroenterology.
- Jamwal, D. R., Marati, R. V., Harrison, C. A., Midura-Kiela, M. T., Figliuolo Paz, V. R., Besselsen, D. G., … & Kiela, P. R. (2020). Total CD3 T Cells Are Necessary and Sufficient to Induce Colitis in Immunodeficient Mice With Dendritic Cell–Specific Deletion of TGFbR2: A Novel IBD Model to Study CD4 and CD8 T-Cell Interaction. Inflammatory bowel diseases, 26(2), 229-241.
- Figliuolo da Paz, V., Jamwal, D. R., Gurney, M., Midura-Kiela, M., Harrison, C. A., Cox, C., … & Kiela, P. R. (2019). Rapid downregulation of DAB2 by toll-like receptor activation contributes to a pro-inflammatory switch in activated dendritic cells. Frontiers in immunology, 10, 304.
- Harrison, C. A., Laubitz, D., Midura-Kiela, M. T., Jamwal, D. R., Besselsen, D. G., Ghishan, F. K., & Kiela, P. R. (2019). Sexual Dimorphism in the Response to Broad-spectrum Antibiotics During T Cell-mediated Colitis. Journal of Crohn’s and Colitis, 13(1), 115-126.
- Harrison, C. A., Laubitz, D., Ohland, C. L., Midura-Kiela, M. T., Patil, K., Besselsen, D. G., … & Kiela, P. R. (2018). Microbial dysbiosis associated with impaired intestinal Na+/H+ exchange accelerates and exacerbates colitis in ex-germ free mice. Mucosal immunology, 11(5), 1329-1341.
- Harrison, C. A., & Taren, D. (2018). How poverty affects diet to shape the microbiota and chronic disease. Nature Reviews Immunology, 18(4), 279.
- Laubitz, D., Harrison, C. A., Midura-Kiela, M. T., Ramalingam, R., Larmonier, C. B., Chase, J. H., … & Kiela, P. R. (2016). Reduced epithelial Na+/H+ exchange drives gut microbial dysbiosis and promotes inflammatory response in T cell-mediated murine colitis. PloS one, 11(4), e0152044.
- McFadden, R. M. T., Larmonier, C. B., Shehab, K. W., Midura-Kiela, M., Ramalingam, R., Harrison, C. A., … & Ghishan, F. K. (2015). The role of curcumin in modulating colonic microbiota during colitis and colon cancer prevention. Inflammatory bowel diseases, 21(11), 2483-2494.